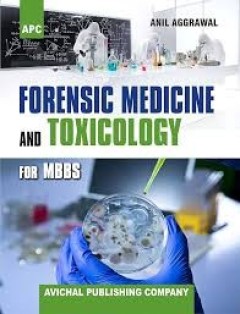
cover

Filter by

Netter's Sports Medicine
Netter\\\\\\\'s Sports Medicine, 3rd Edition is a highly visual, comprehensive, and interdisciplinary guide for clinicians treating athletes of all levels. Edited by experts including three past AMSSM presidents, it features >1,000 Netter illustrations, images, and bulleted text, covering injury, prevention, and rehabilitation, with new updates on esports, ultrasound, and cardiac health.
- Edition
- 3rd
- ISBN/ISSN
- 9780323395915
- Collation
- xix,766p.:ills;28cm.
- Series Title
- -
- Call Number
- 616.1/027 NET

Mims' Medical Microbiology and Immunology
Mims\' Medical Microbiology and Immunology (6th Edition) provides a systems-based, clinically oriented approach to understanding microbes and host responses. It covers the fundamentals of microbiology, immunology, and infectious diseases, focusing on how pathogens interact with body systems, featuring key concept boxes, \"Lessons in Microbiology,\" and an extensive online \"Pathogen Parade\"
- Edition
- 6th
- ISBN/ISSN
- 9780702071546
- Collation
- xv,552p.:ills;27cm.
- Series Title
- -
- Call Number
- 616.9041 GOM

Lippincott's Illustrated Reviews Immunology
Lippincott\\\'s Illustrated Reviews: Immunology, 2nd Edition by Doan et al. is a highly visual, outline-format review text designed for medical and health professional students. It features over 300 full-color annotated illustrations, chapter summaries, and case studies to bridge basic immunology principles (innate/adaptive immunity) with clinical applications like hypersensitivity and autoimmu…
- Edition
- 2nd Indian rep.
- ISBN/ISSN
- 9788184737639
- Collation
- v,376p.:ills;27cm.
- Series Title
- -
- Call Number
- 616.079 DOL

Medical Microbiology
Turn to Medical Microbiology, 8th Edition for a thorough, clinically relevant understanding of microbes and their diseases. This succinct, easy-to-use text presents the fundamentals of microbiology and immunology in a clearly written, engaging manner-effectively preparing you for your courses, exams, and beyond. Coverage of basic principles, immunology, laboratory diagnosis, bacteriology, virol…
- Edition
- 8th
- ISBN/ISSN
- 9780323299565
- Collation
- x,836p.:ills;27cm.
- Series Title
- -
- Call Number
- 616.9041 MUM

Kuby Immunology
Kuby Immunology, Eighth Edition, is authored by experts in the field and covers a comprehensive overview of the immune system, including innate and adaptive immunity, immune responses in health and disease, and experimental methods.
- Edition
- 8th
- ISBN/ISSN
- 9781319114701
- Collation
- xxviii,805p.:ills;27cm.
- Series Title
- -
- Call Number
- 616.079 PUK

Rashid, Khabir, Hyder's Textbook of Community Medicine and Public Health
- Edition
- 5th
- ISBN/ISSN
- 9843213394
- Collation
- xv,626p.:ills;27cm.
- Series Title
- -
- Call Number
- 614.44 RAS
- Edition
- 5th
- ISBN/ISSN
- 9843213394
- Collation
- xv,626p.:ills;27cm.
- Series Title
- -
- Call Number
- 614.44 RAS

Forensic Medicine & Toxicology for MBBS
Forensic Medicine & Toxicology for MBBS (1st Ed.) by Prof. Anil Aggrawal is a concise, exam-oriented textbook designed for undergraduate medical students, published by Avichal Publishing Company. It simplifies complex topics like autopsy, injuries, and poisons using diagrams, flowcharts, and memory aids. The book includes updated legal procedures, MCQs, and practical tips, making it a comprehen…
- Edition
- 1st rep.
- ISBN/ISSN
- 9788177394917
- Collation
- xxvi,694p.:ills;27cm.
- Series Title
- -
- Call Number
- 614.1 AGF

Principles of Forensic Medicine & Toxicology
The Principles of Forensic Medicine and Toxicology depicts legal procedure, medical jurisprudence, medical evidence, legal aspects of medical practice related to forensic medicine and toxicology. Major topics of discussion include consumer protection act, procedure in court, or ethics and medical research related to toxicology, forensic osteology, regional injuries, road traffic accidents, ther…
- Edition
- 2nd
- ISBN/ISSN
- 9789386150318
- Collation
- xix,627p.:ills;26.5cm.
- Series Title
- -
- Call Number
- 614.1 BAP

Rang & Dale's Pharmacology
The fully revised 9th Edition keeps you up to date with all that’s new in the field, including new and emerging drugs and recent studies. From cover to cover, you’ll progressively increase your knowledge of all relevant aspects of pharmacology, from a molecular understanding of receptors and drug actions through clinical uses of key groups of drugs.
- Edition
- 9th
- ISBN/ISSN
- 9780702074486
- Collation
- xvi,789p.:ills;27cm.
- Series Title
- -
- Call Number
- 615.1 RIR
Clinical Pharmacology
The 12th edition of Clinical Pharmacology by Morris J. Brown (published 2018/2019) is a comprehensive, updated guide bridging basic science with evidence-based prescribing. It features system-based coverage, case studies, and practical advice for complex, polypharmacy, or developing-world contexts, focusing on safe, effective drug therapy
- Edition
- 12th
- ISBN/ISSN
- 9780702073281
- Collation
- xiii,706p.:ills;23cm.
- Series Title
- -
- Call Number
- 615.1 BRC
 Computer Science, Information & General Works
Computer Science, Information & General Works  Philosophy & Psychology
Philosophy & Psychology  Religion
Religion  Social Sciences
Social Sciences  Language
Language  Pure Science
Pure Science  Applied Sciences
Applied Sciences  Art & Recreation
Art & Recreation  Literature
Literature  History & Geography
History & Geography